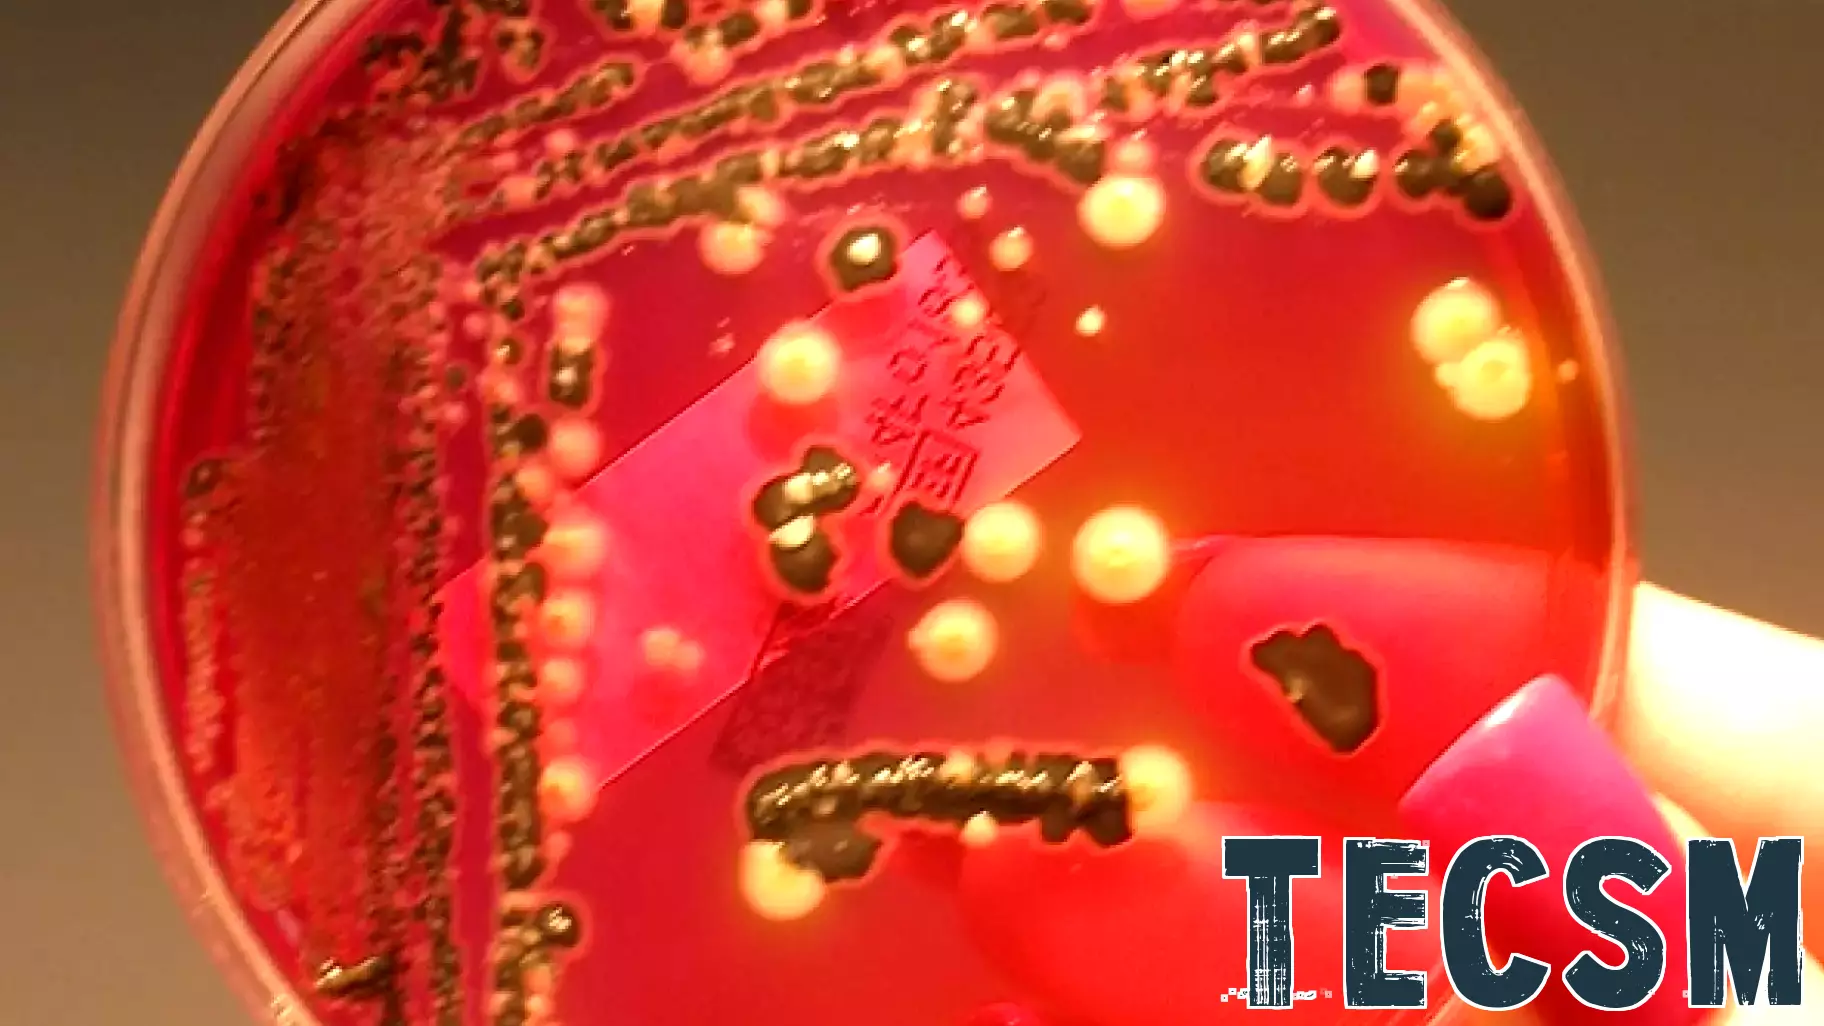

September 10, 2025 - 07:32
The detection of strong, unpleasant odors in food often signals bacterial contamination, indicating that the food is no longer safe for consumption. However, harmful pathogens like salmonella and E. coli can be challenging to identify, posing significant risks to public health. To address this pressing issue, researchers are developing advanced electronic nose technology designed to enhance food safety measures.
This cutting-edge technology mimics the human sense of smell, utilizing an array of sensors to detect specific volatile compounds associated with spoilage and contamination. By analyzing the chemical signatures of food products, the electronic nose can quickly and accurately identify potential threats, enabling timely intervention before contaminated food reaches consumers.
The implementation of this technology in food processing and distribution could significantly reduce the incidence of foodborne illnesses. As it continues to evolve, electronic nose technology promises to become an essential tool in ensuring the safety and quality of food, ultimately protecting public health and enhancing consumer confidence.
March 3, 2026 - 02:44
Conservation Tillage and Technology Conference is March 10-11The future of sustainable agriculture will be the focus at the 2026 Conservation Tillage and Technology Conference, scheduled for March 10-11. The event, to be held at Ohio Northern University in...
March 2, 2026 - 10:58
A Look At GigaCloud Technology (GCT) Valuation After Record Results And New Buyback ProgramGigaCloud Technology (GCT) has captured significant market interest following the release of its outstanding fourth-quarter and full-year 2025 financial results. The company announced...
March 1, 2026 - 18:14
Gibran Jones discusses technology’s role in the future of workAs artificial intelligence continues to reshape industries, workplaces, and public conversations, a leading voice urges a focus on its collaborative potential. According to digital strategist and...
March 1, 2026 - 02:48
Brown And Brown Taps Dori Henderson To Drive Technology And AI ShiftBrown & Brown has named Dorothea `Dori` Henderson as its Chief Information Technology Officer, a strategic hire aimed at accelerating the firm`s technological evolution. Henderson will be directly...